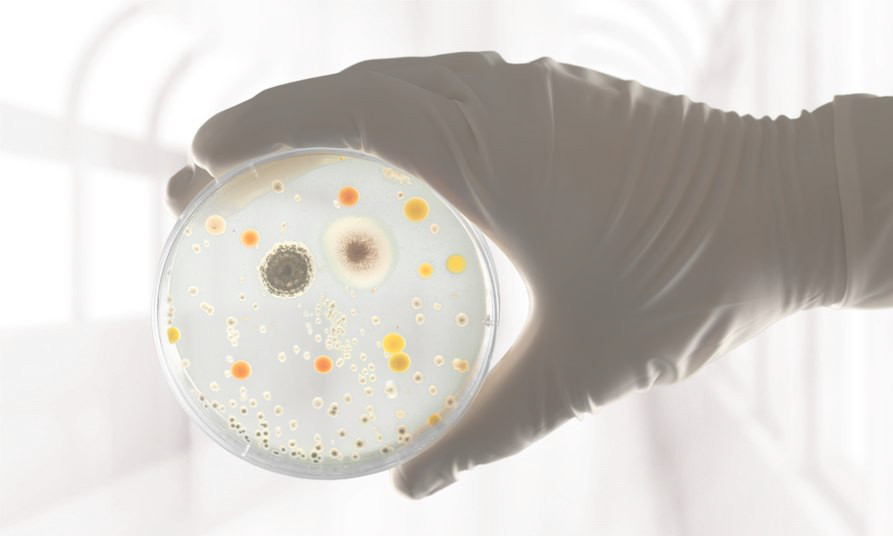

Lors de la construction d’un bâtiment, les architectes et les propriétaires se confrontent à un véritable casse tête de sélection de l’emplacement de l'interrupteur. Leur position étant fixe et demandant beaucoup d'efforts dès lors que l’on veut déplacer un meuble ou modifier légerement la disposition des meubles par exemple.

L’accessibilité à l’interrupteur devient souvent complexe pour les personnes à mobilité réduite. Pour cela il existe des normes de hauteurs d’interrupteur mieux adaptées qui obligent à descendre la hauteur traditionnelle prévue à la construction. Les travaux deviennent alors obligatoires et ne demmandent pas seulement de descendre l'interrupteur mais de retravailler l'ensemble du mur pour combler l'emplacement de l'ancien interrupteur.
Avec les capteurs de présence, ou les caméras, les interrupteurs représentent des nids à bactéries qui viennent se nicher dans leurs interstices. Ce problème se retrouve surtout dans les laboratoires de pointe, les espaces de recherches et lieux de santé ainsi que dans l’agro-alimentaire.

Pour répondre à ces attentes en terme d'emplacement et d'accessibilité de nombreux objets connectés ont été développés. Ils se controlent par la voix, ou ils captent votre présence par un système vidéo. Mais ces solutions peuvent paraîtrent intrusives. La gestion des données de ces objets connectés reste un sujet sensible dans les habitations privées et les hôtels par exemple.
Talkative Matter est une technologie au service du design, adaptable et fonctionnelle, qui offre la possibilité d'imaginer l'interrupteur universel de demain.
Talkative Matter est une technologie au service du design, adaptable et fonctionnelle, qui offre la possibilité d'imaginer l'interrupteur universel de demain.